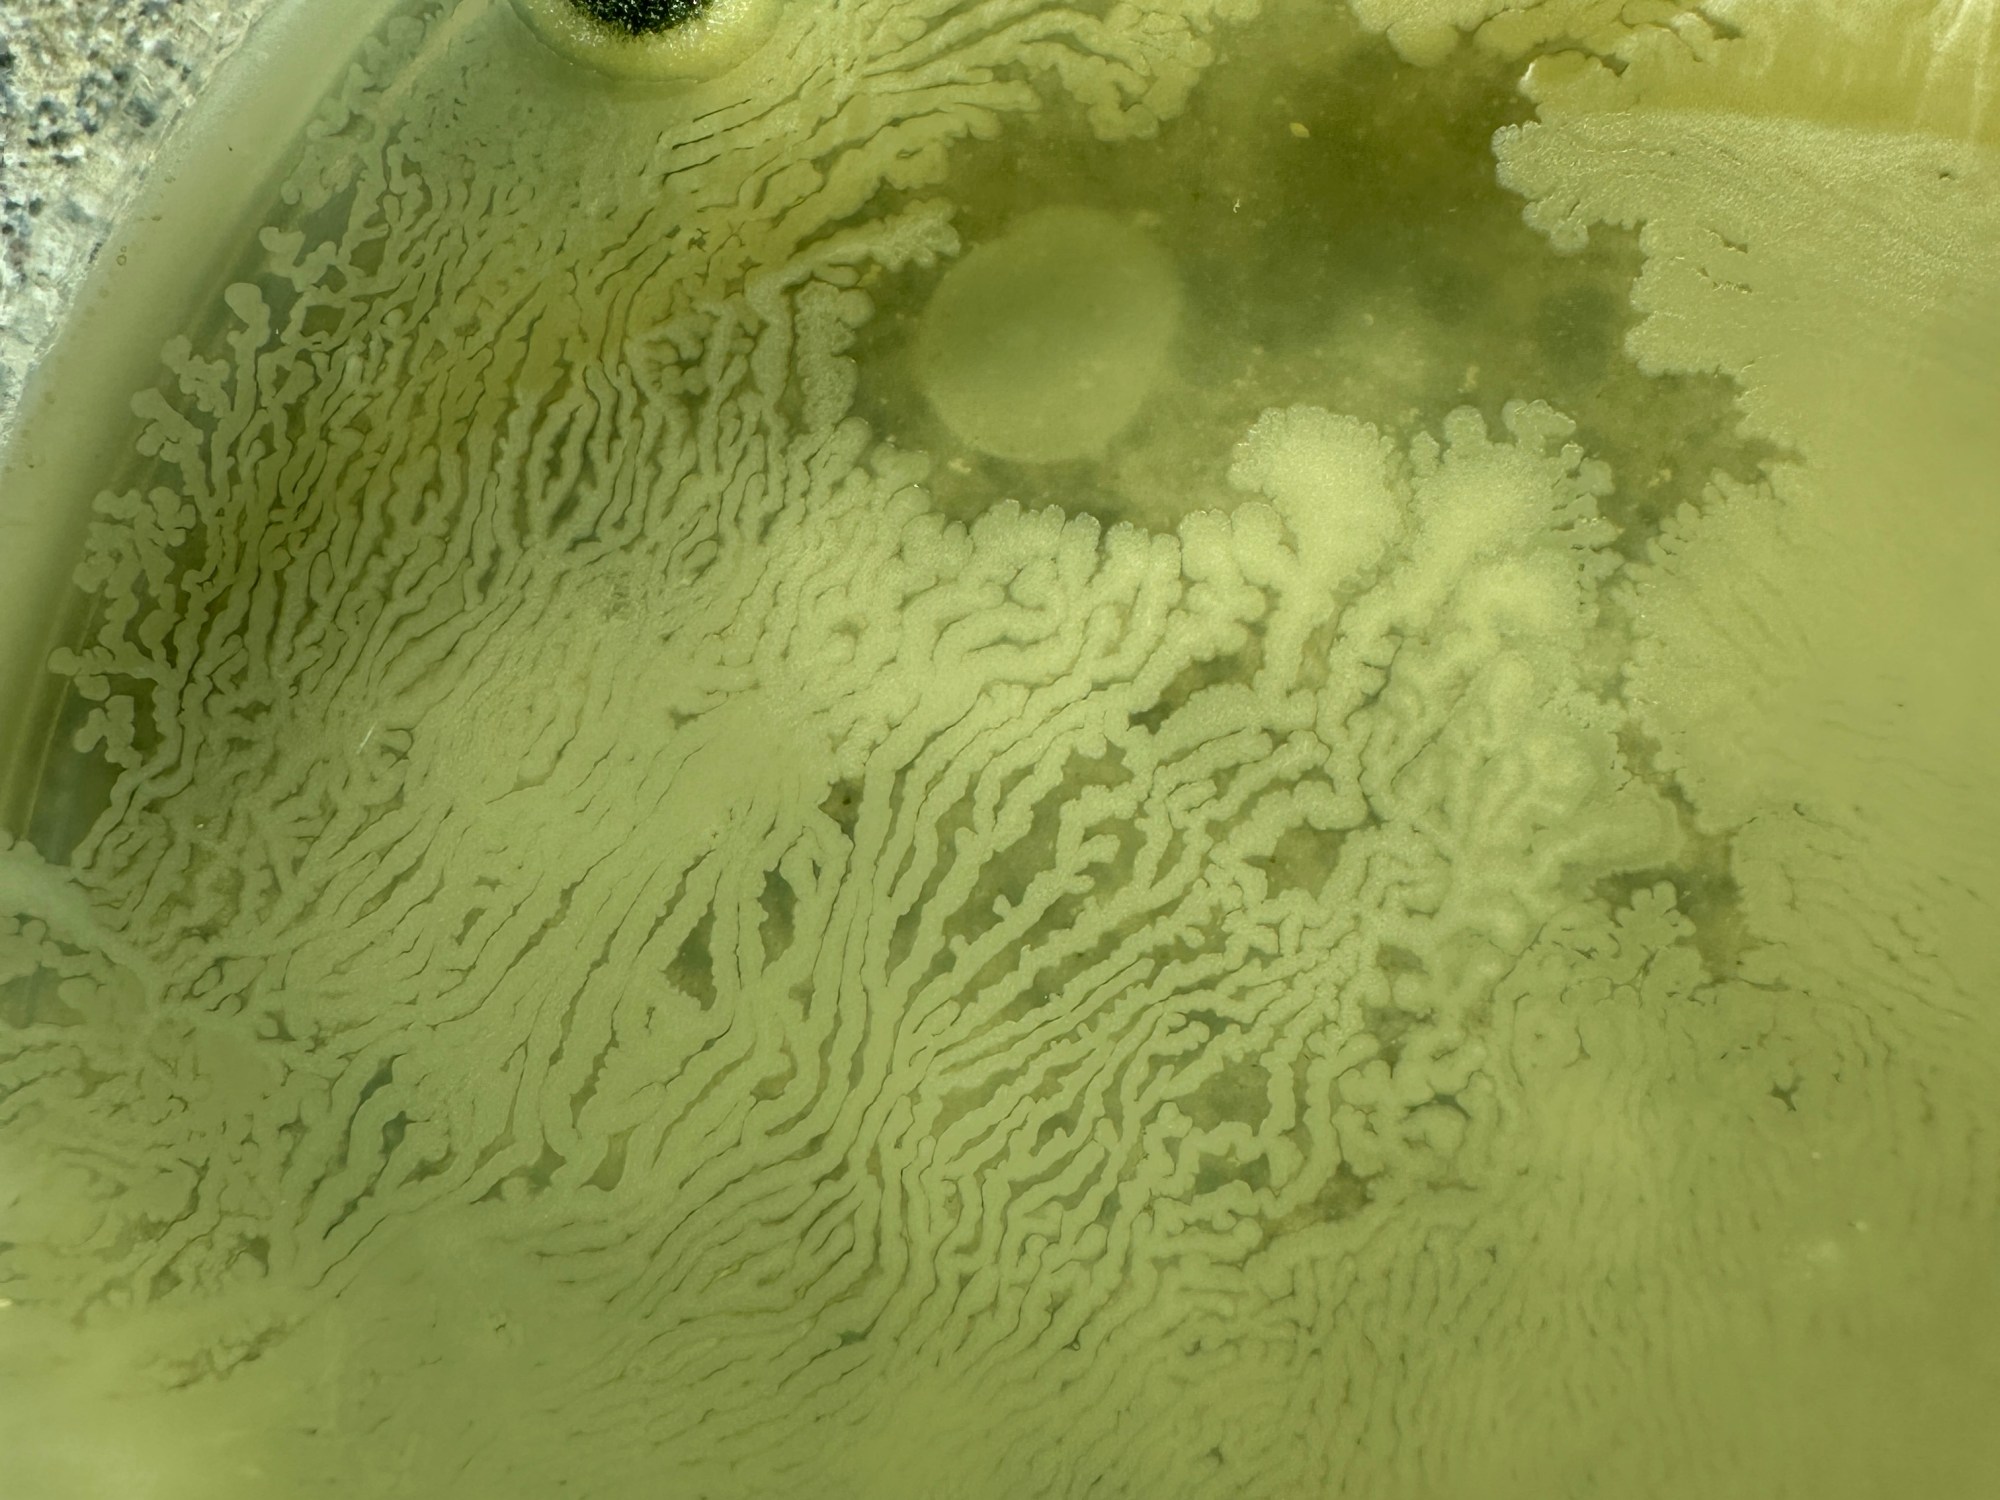

WhiteFeather will lead a two-day workshop, titled Dirty Design: Bacterial Kin and the Politics of Contamination at the SFU School of Interactive Arts & Technology, on Mar 25 and 27th, 10am-1pm.
Laboratories traditionally operate under conditions of sterility, but what happens when contamination becomes the method? Humans are ecosystems hosting trillions of microbial companions that shape digestion, immunity, mood, smell, and cognition. We consume bacteria constantly: yogurt, kimchi, kombucha, sourdough, cheese. What about bacteria originating from our own bodies? Microorganisms are the most abundant material engineers on Earth. In this workshop we suspend the ideology of asepsis and instead explore microbial intimacy as a material practice. Participants will culture bacteria from their own bodies onto custom nutrient media, including recipes using both laboratory and grocery materials, to transform the petri dish into a sort of biological self-portrait. Through hands-on experiments that include swabbing, culturing and discussion, we will explore bacteria as cohabiting life forms that transgress the boundaries of the human body.
The workshop is by invite only, offered through the Organic Materials Research Lab (Ron Wakkary, PI), where WhiteFeather serves as Senior Materials Innovation and Lab Development Advisor.
Photo credit: Gabriela Aceves-Sepúlveda.